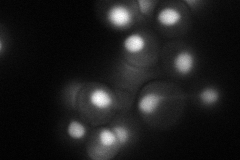
YKL095W
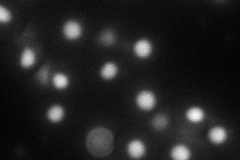
YKL095W
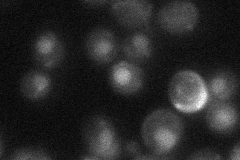
YKL095W
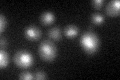
YKL095W

View description
Essential protein required for pre-mRNA splicing; associates transiently with the spliceosomal NTC ("nineteen complex") and acts after Prp2p to promote the first catalytic reaction of splicing
Localization:
Intensity:
Fold change:
Significance:
-
C’ GFP library in SD

nucleus27.55 -
N' NOP1pr-GFP in SD
nucleus66.7115 -
N' TEF2pr-mCherry in SD
nucleus67.4012 -
N' NATIVEpr-GFP in SD
nucleus27.0406 -
N' TEF2pr-VC and Cyto-VN in SD

#N/A0 -
C’ GFP library in SD+DTT
nucleus26.730.97No -
C’ GFP library in SD+H2O2

nucleus26.240.95No -
C’ GFP library in Starvation Media

nucleus19.480.7Yes -
C’ GFP library on the background of Pup2-DaMP

nucleus -
C’ GFP library on the background of CCT mutant

nucleus29.01261.05278No
